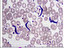
swidrowiec gambijski po polsku

Moja lekcja
0 1 fiszka guest3914357
ściągnij mp3
drukuj
graj sprawdź się
Idealne dla słuchowców – zamień swoje słówka w audiokurs i ucz się:
podczas jazdy autobusem czy samochodem
na spacerze z psem
czekając w kolejce
przed snem
Funkcja dostępna tylko dla użytkowników premium.
aktywuj konto premium przykładowe nagranie
podczas jazdy autobusem czy samochodem
na spacerze z psem
czekając w kolejce
przed snem
Funkcja dostępna tylko dla użytkowników premium.
aktywuj konto premium przykładowe nagranie
Idealne poza domem – wydrukuj swoje słówka:
jako poręczną listę
jako fiszki do wycięcia
Funkcja dostępna tylko dla użytkowników premium.
aktywuj konto premium przykładowy wydruk
jako poręczną listę
jako fiszki do wycięcia
Funkcja dostępna tylko dla użytkowników premium.
aktywuj konto premium przykładowy wydruk
Pytanie  |
Odpowiedź  |
|||
|---|---|---|---|---|
| rozpocznij naukę | |
|||
Musisz się zalogować, by móc napisać komentarz.

zgłoś błąd
Dziękujemy za zgłoszenie :)
Brawo, świetnie Ci idzie:)
Twórcą tych fiszek jest Guest3914357. Kliknij, aby stworzyć własne fiszki:)
Jeśli wolisz gotowe, wypróbuj nasze profesjonalne kursy.
Jeśli wolisz gotowe, wypróbuj nasze profesjonalne kursy.
Powtórz wszystkie
Powtórz trudne
Koniec rundy 1
Podsumowanie
| runda | wiem | nie wiem |
|---|---|---|
| 1 | () | () |
Następna runda
powtórz to, czego nie wiedziałeś
- English
- American English
- Français
- español
- Nederlands, Vlaams
- Deutsch
- Norsk
- język polski
- português
- русский язык
- Svenska
- українська мова
- italiano
- gjuha shqipe
- العربية
- euskara
- беларуская мова
- български език
- 中文, 汉语, 漢語
- hrvatski jezik
- český jazyk
- dansk
- Esperanto
- eesti keel
- føroyskt
- suomen kieli
- galego
- ελληνικά
- ქართული
- עברית
- हिन्दी, हिंदी
- Bahasa Indonesia
- Íslenska
- 日本語, にほんご
- ייִדיש
- ಕನ್ನಡ
- català, valencià
- Қазақша
- isiXhosa
- 한국어, 韓國語, 조선어, 朝鮮語
- latine
- lietuvių kalba
- latviešu valoda
- Lëtzebuergesch
- македонски јазик
- bahasa Melayu, بهاس ملايو
- Malti
- Papiamento
- فارسی
- Português brasileiro
- rumantsch grischun
- limba română
- српски језик
- Setswana
- slovenský jazyk
- slovenski jezik
- Gàidhlig
- ไทย
- Xitsonga
- Türkçe
- اردو
- magyar
- Tiếng Việt
- isiZulu
Zaznacz prawidłową odpowiedź
Odkryj wszystkie pary w najmniejszej liczbie ruchów!
0 kroków
Nowa gra:

